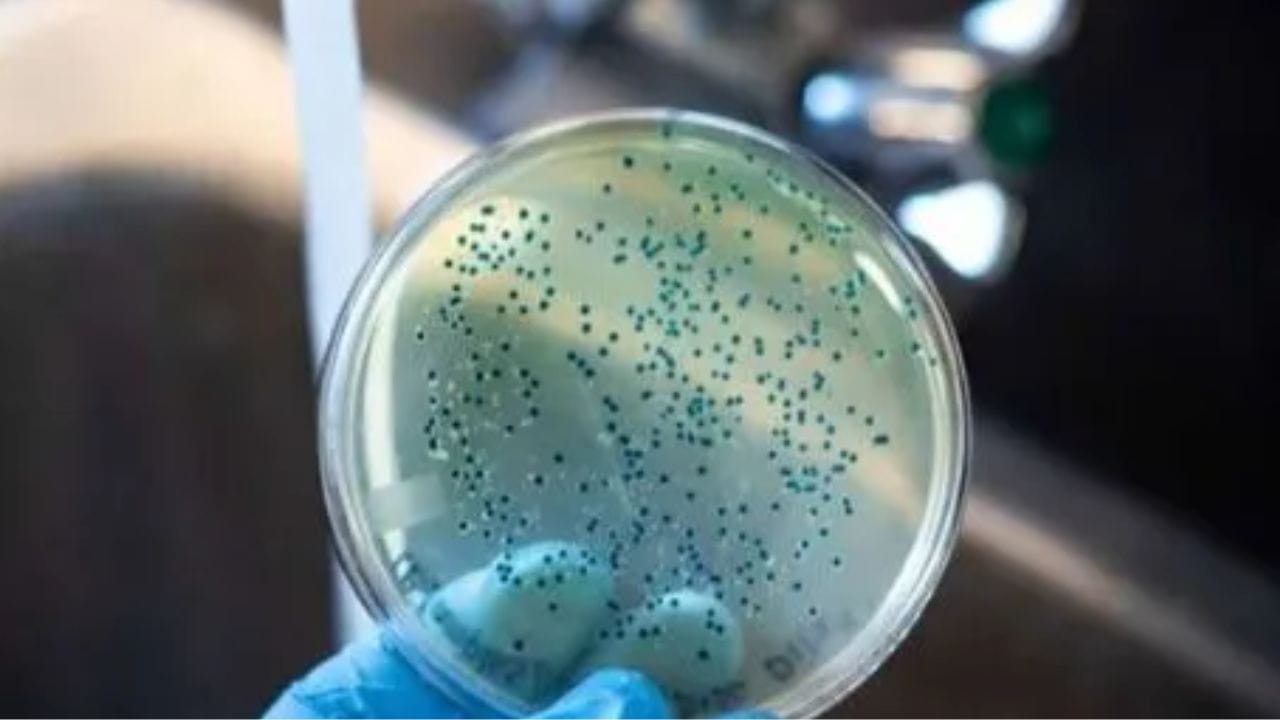
നെയ്യാറ്റിന്കര ഭിന്നശേഷിക്കാരുടെ ഹോസ്റ്റലിലെ അന്തേവാസിയായ അനുവാണ് (26) കോളറ ലക്ഷണങ്ങൾ കാണിക്കുകയും തുടർന്ന് മരണത്തിനു കീഴടങ്ങുകയും ചെയ്തത്. അനുവിനൊപ്പം വയറിളക്കം ബാധിച്ച കുട്ടിക്ക് കോളറ സ്ഥിരീകരിച്ചിരുന്നു. ഹോസ്റ്റലിലെ ഒമ്പത് അന്തേവാസി വയറിളക്കം ബാധിച്ചതിനേത്തുടർന്ന് മെഡിക്കല് കോളജ് ആശുപത്രിയിലാണ്. മരിച്ച അനുവിന് കോളറ ബാധിച്ചിരുന്നോയെന്ന് കണ്ടെത്താന് പരിശോധന നടത്തും. സംസ്ഥാനത്ത് കഴിഞ്ഞ 6 മാസത്തിനിടെ 9 പേര്ക്കാണ് കോളറ സ്ഥിരീകരിച്ചത് എന്നാണ് വിവരം. ഒടുവിലായി 2017ലാണ് സംസ്ഥാനത്ത് കോളറ ബാധിച്ച് മരണം സംഭവിക്കുന്നത്.

Cholera : സംസ്ഥാനം വീണ്ടും കോളറ ഭീതിയിലേക്കോ? അറിയാം ലക്ഷണങ്ങളും പ്രതിരോധവും
Kerala Cholera: തിരുവനന്തപുരത്ത് കോളറ ബാധിച്ചാണോ യുവതി മരിച്ചത് എന്ന സംശയം ഉയർന്നതോടെ സംസ്ഥാനം വീണ്ടും ഭീതിയിലേക്ക്. എസ്എടിയില് ചികിത്സയിലുള്ള കുട്ടിക്ക് മെഡിക്കല് കോളജ് ആശുപത്രി ലാബിലെ പരിശോധനയിലാണ് രോഗം സ്ഥിരീകരിച്ചത്.
1 / 5

2 / 5

3 / 5

4 / 5

5 / 5
Follow Us